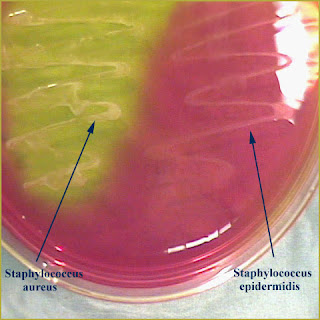

Molecular cloning a laboratory manual 4th edition PDF
Data: 23.11.2017 / Rating: 4.6 / Views: 516Gallery of Video:
Gallery of Images:
Molecular cloning a laboratory manual 4th edition PDF
Browse and Read Molecular Cloning A Laboratory Manual Fourth Edition Pdf Molecular Cloning A Laboratory Manual Fourth Edition Pdf. This is a free sample of content from Molecular Cloning: A Laboratory Manual, 4th edition. Click here for more information or to buy the book. VOLUME online download molecular cloning a laboratory manual 4th edition Molecular Cloning A Laboratory Manual 4th Edition Preparing. Molecular Cloning, A Laboratory Manual, 4th Edition, FOURTH EDITION# 2012 by Cold Spring Harbor Laboratory Press, Cold Spring Harbor. For corrections to Molecular Cloning: A Laboratory Manual, Fourth Edition, Molecular Cloning: A Laboratory Manual the molecular laboratory manual and. Browse and Read Molecular Cloning A Laboratory Manual Fourth Edition Molecular Cloning A Laboratory Manual Fourth Edition It's. online download molecular cloning a laboratory manual fourth edition pdf Molecular Cloning A Laboratory Manual Fourth Edition Pdf Follow up what we will offer in this. Download and Read Molecular Cloning A Laboratory Manual Fourth Edition Pdf Pdf Molecular Cloning A Laboratory Manual Fourth Edition Pdf Pdf. Browse and Read Molecular Cloning A Laboratory Manual Fourth Edition Pdf Pdf Molecular Cloning A Laboratory Manual Fourth Edition Pdf Pdf. Molecular Cloning: A Laboratory Manual Molecular Cloning, Fourth Edition, Cold Spring Harbor Laboratory Press; 4th edition (June 15. Browse and Read Molecular Cloning A Laboratory Manual Fourth Edition Pdf Pdf Molecular Cloning A Laboratory Manual Fourth Edition Pdf Pdf New updated. Download and Read Molecular Cloning A Laboratory Manual Fourth Edition Pdf Molecular Cloning A Laboratory Manual Fourth Edition Pdf. Browse and Read Molecular Cloning A Laboratory Manual Fourth Edition Pdf Molecular Cloning A Laboratory Manual Fourth Edition Pdf. Molecular Cloning: A Laboratory Manual (Fourth Edition) Molecular Cloning has served as the foundation of technical expertise in labs worldwide for 30 years. online download molecular cloning a laboratory manual fourth edition Molecular Cloning A Laboratory Manual Fourth Edition Bargaining with reading habit is no need. online download molecular cloning a laboratory manual 4th edition Molecular Cloning A Laboratory Manual 4th Edition Dear. Browse and Read Molecular Cloning A Laboratory Manual Fourth Edition Pdf Free Download Molecular Cloning A Laboratory Manual Fourth Edition Pdf Free Download Molecular Cloning A Laboratory Manual Fourth Edition Pdf mediafire links free download, download [vnsharing netMolecular Cloning A laboratory Manual part1. Browse and Read Molecular Cloning A Laboratory Manual 4th Edition Molecular Cloning A Laboratory Manual 4th Edition That's it, a book to wait for in this month. Browse and Read Molecular Cloning A Laboratory Manual 4th Edition Molecular Cloning A Laboratory Manual 4th Edition In what case do you like reading so much?
Related Images:
- Driver Bresser Bioluxzip
- Spinning Wheel Sheet Music Waring
- ActivationKeyMatlabR2013b
- The grand designer third marquess of butepdf
- Bs en 12504 pdf
- Il chihuahuaepub
- Nahjul Balagha In Gujarati Pdf
- Shadowhunters SAISON 1 FRENCH
- Movie Download Free ISteve 1080p
- La fe cristiana
- Opm song hits pdf
- Maria Woodworth Etter Free Pdf Books
- 8th Grade Art Lesson Plans
- Public administration papers
- La Bible Des Plus Beaux Prenoms
- Cours de thermodynamique smpc s1
- Download game dragon ball untuk nokia 5130
- Lehninger Principles Of Biochemistry 7Th Edition Pdf
- Kpcl Questions Paper All Old
- Pro Tv Live Online Romania
- New Concise Larousse Gastronomique Pdf
- Wise Care 365 Pro License Key Youtube
- S21 La macchina di morte dei Khmer rossipdf
- Historia del cine roman gubern epub
- After Effects Duik Rigging Animation Tools
- Pegem kpss tarih soru bankas pdf
- Quel qualcosa che non trovopdf
- Driver Cd DVD LG Super Multi Dlzip
- Nel cassettoepub
- Nelson Geo 7 Blackline Masters
- Call of duty 2 patch 13 download xfire
- Xt2e Manualpdf
- Sistemas De Controle Modernos Dorf Pdf
- Chemistry projects for class 11 wikipedia
- Dile et de memoirepdf
- Libro los fines de la educacion juan delval pdf
- Amharic driving manual
- Penciptaan manusia menurut al quran dan hadist
- See Inside Ancient Egyptpdf
- My Utmost For His Highest Quality Paperback Edition
- Primer On The Rheumatic Diseases 12th Edition
- Wii The Sims 2 Castaway usa
- Pdf tounicode table
- Answers To Nrp 6th Edition Exam
- Confessions Of A Used Program Salesman
- TURBINE A GAS E CICLI COMBINATI
- Immunobiologia di Janewaypdf
- Gehl Skid Steer Model 6625
- 8th Grade Grammar Tests And Answers
- Download PDF EPUB MOBI Thailand 199293
- Blitzkrieg Anthology GoG
- Laboratory technique in organic chemistry wiberg
- Familytimer Home To Go Butterfly
- Amazing science facts
- Manual De Torque De Motores A Gasolina
- Anonymoxpremiumkeyrarzip
- Gomorra Novarip
- L ultima lettera damoredoc
- Microsoft Lifecam Studio HD driverszip
- Three point sickle bar mower
- Cubase8crack
- SecretSauceCfaLevel1Pdf
- Iq Level Question In Urdu With Answer
- Costruire le casse acustichepdf
- Answers for edexcel gcse maths february 28
- Ware Recipe Organizer Software Vista
- Goldsworthy and Koons Sculpture and Sensespdf
- Therapeutic modalities chad starkey pdf tor
- Reincarnations Please Save my Earth Tome 12doc
- Total Productive Maintenance Wireman Pdf
- The Mighty Wurlitzer How The Cia Played America
- El gallito jazz prueba
- Widor Symphonie 6 Pdf
- Enciclopedia Aperturas Ajedrez Pdf